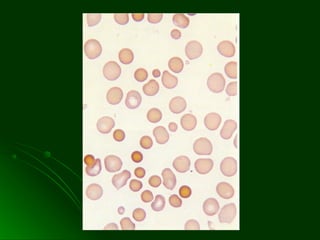

Este documento describe las anemias hemolíticas, incluyendo sus causas, manifestaciones clínicas y de laboratorio. Explica en detalle la esferocitosis hereditaria, la deficiencia de G6PD y la drepanocitosis. Proporciona información sobre el diagnóstico y tratamiento de estas condiciones.